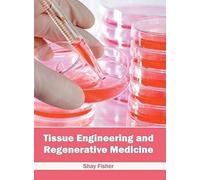
Tissue Engineering And Regenerative Medicine

![Tissue Engineering and Regenerative Medicine - [Version Originale] Joseph P Vacanti (Auteur)](https://cdn.prix.net/offer/fr/tissue-engineering-and-regenerative-medicine-version-originale-joseph-p-vacanti-auteur-200t1809ca4bc565cc1c230eb810d60ff90704d3f7a37d1.jpg)

- 1
- 2
- page suivante
🤖 Demande à ChatGPT
tissue engineering and - Comparez les prix parmi 87 offres disponibles chez nos partenaires et achetez moins cher.
Nos partenaires proposent tissue engineering and parmi les catégories Livres & magazines, Fasciathérapie mais aussi Manucure. Vous souhaitez affiner votre recherche pour trouver le meilleur produit ? Utilisez les filtres ou essayez d'autres mots-clés plus adaptés.
Quel est le meilleur prix pour tissue engineering and ?
3,69 € est le prix le plus aventageux et vous est proposé par Amazon.fr le 2025-12-17. Les prix peuvent évoluer dans la journée ou dans les prochains jours. Revenez un autre jour si vous voulez comparer les prix.
Vous pourrez commander tissue engineering and au meilleur prix chez Amazon.fr et bien d'autres.
Le partenaire le plus adapté à votre tissue engineering and est Rakuten.com FR. amazon-marketplace.fr, Amazon.fr proposent également des prix très aventageux parmi nos 4 boutiques partenaires qui proposent ce produit. Notre comparateur de prix vous donne accès aux prix de centaines de marchands présent sur internet.
Liste des marchands proposant la recherche tissue engineering and:
- Rakuten.com FR
- amazon-marketplace.fr
- Amazon.fr
- Fnac.com (Marketplace)
tissue engineering and Amazon.fr
Amazon.fr vous propose tissue engineering and. Ce shop a rempli nos critères de sélection en remplissant toutes nos conditions de sécurité et de garantie.
tissue engineering and est en vente en ligne et est proposé par plusieurs marques sur internet.
Cette recherche est disponible parmi deux marques. Vous pourrez choisir ce produit chez Springer Verlag ou chez Generique
Il n'y a pas de recherche similaire à cet requête. Choississez un autre produit le moteur de recherche de produit de prix.net si vous êtes intéressé par un produit ressemblant ou s'y raprochant.
Aucun renseignement concernant une couleur est indiqué ou renseigné par le marchand en ligne pour cette requête.
Comparer les prix avant tous achats en ligne
Les comparateurs de prix sont un allié essentiel pour vos achats en ligne. Quelque soit le produit que vous recherchez, vous pourrez le trouver au prix actuel et le moins cher parmi toutes les offres de nos partenaires. Avant chacune de vos commandes en ligne, il vous suffira de checker sur prix.net quel marchand propose le prix le plus intéressant. Parmi les informations indiquées, vous trouverez également les différents modes de paiement proposé par le commerçants. Les frais et délais de livraison sont également indiquées dans les informations.
Comment fonctionne notre comparateur de prix ?
On perd parfois de longues heures à rechercher le meilleur prix pour un produit. Fini cette perte de temps inutile, grâce au comparateur de prix, prix.net, nous faisons le travail pour vous. Nous analysons les offres de nos partenaires plusieurs fois par jour, parmi des centaines de milliers de produits. Quelque soit votre recherche, nous vous proposerons le meilleur prix de nos partenaires en temps parmi tous les marchands recensés sur prix.net. Sur un seul et unique site, vous pourrez ainsi trouver tout ce qui vous faut à prix malin et réalisez de bonnes affaires !